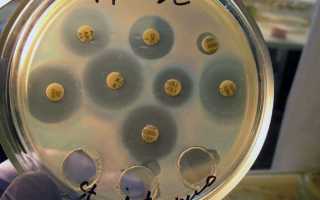

Что показывает метод бактериального посева урины?
В условиях лабораторных исследований мочу помещают в специальную среду, благоприятную для развития и роста микроорганизмов. Причем для каждого из микроорганизмов необходимо своя среда обитания с правильно выбранным кислотным и водным балансом.
Если бактерии не распространяются по поверхности мочи, тогда тест считается отрицательным.
При повышенном размножении микроорганизмов специалисты делают вывод о положительных результатах. В таком случае пациенту нужно всерьез подумать о своем здоровье и не затягивать с проведением лечения.
Для того чтобы с точностью определить вид бактерий, поселившихся в организме человека, они проводят ряд специальных исследований. Если инфекция была обнаружена, на ней испытывают действие некоторых антибиотиков.
Посев мочи берут для того чтобы выявить количество патогенных микроорганизмов и установить возможные лекарственные препараты, которыми можно от них избавиться.
При подобном исследовании специалисты лаборатории ориентируются на нормативные показатели, установленные для медицинских стандартов.
Определение чувствительности уропатогенам к антибиотикам производится одним из трех методов, рекомендованных европейским комитетом по антибиотикорезистентности:
- 1Дисковым методом – на поверхность агара в чашке Петри наносят взвесь бактерий заранее известной плотности, затем помещают сверху диски, содержащие определенную концентрацию антибиотика, что приводит к появлению зоны подавления роста бактерий, по диаметру которой судят о чувствительности микроорганизма и определяют минимальную подавляющую концентрацию препарата;
- 2Градиентно-диффузным Е-тестом – метод схож с дисковым, однако вместо антибактериальных дисков используются полоски с Е-тестом, содержащие концентрационный градиент антибиотика от минимума к максимуму. В данном случае также определяется минимальная подавляющая концентрация препарата;
- 3Методом серийных разведений – антибиотик разводится в нескольких, заранее известных концентрациях, после чего вводится в агар для культивирования бактерий. По степени подавления бактериального роста также можно судить о наличии или отсутствии чувствительности к антибиотику.
Этот анализ выявляет и идентифицирует микроорганизмы, содержащиеся в урине. По результатам определяют их концентрацию, что позволяет установить уровень, на котором находится развитие аномальных изменений в организме индивида.
Бесспорное преимущество анализа мочи на
заключается в его высокой информативности и правильности результатов. Итоги лабораторных исследований дают уникальную информацию, которую невозможно получить с помощью других методов. К некоторым неудобствам следует отнести длительный срок проведения и увеличенные требования к чистоте обследуемого материала. Очень часто бак посев проводится для установления диагноза на следующие болезни:
- микоплазмоз – поражается мочеполовая система;
- уреаплазмоз – инфекция атакует половые органы;
- трихомониаз – самая распространенная инфекция мочеполовой системы в мире;
- кандидоз – развивается на фоне сниженного иммунитета.
Урологический посев является важным диагностическим методом, который позволяет выявить наличие инфекций в мочевыводящих путях. Врачи подчеркивают, что этот анализ помогает определить не только наличие патогенных микроорганизмов, но и их чувствительность к антибиотикам. Это особенно актуально в условиях растущей антибиотикорезистентности. Специалисты отмечают, что посев мочи рекомендуется проводить при наличии симптомов инфекций, таких как боль при мочеиспускании, частые позывы или изменение цвета мочи. Результаты анализа позволяют врачам назначить наиболее эффективное лечение, что значительно ускоряет процесс выздоровления и снижает риск осложнений. Таким образом, урологический посев является ключевым инструментом в практике урологов и терапевтов.
Урологический посев — это важный диагностический метод, который позволяет выявить наличие инфекций в мочевыводящих путях. Многие пациенты отмечают, что процедура довольно проста и безболезненна. Обычно для анализа берется моча, которая затем помещается в специальную среду для роста бактерий. Результаты помогают врачам определить, какие микроорганизмы вызывают инфекцию, и подобрать соответствующее лечение. Люди часто делятся, что благодаря посеву удается избежать назначения ненужных антибиотиков и снизить риск осложнений. Кроме того, многие отмечают, что такой анализ помогает в профилактике рецидивов заболеваний. В целом, урологический посев воспринимается как важный шаг к восстановлению здоровья и улучшению качества жизни.

Бывает ли боль после мазка из уретры у мужчин?
Чтобы получить материал для исследования в необходимом объеме, в канал уретры мужчины вводят зонд на глубину около 3 см. При проведении данной процедуры обязательно используется одноразовый стерильный инструмент. После введения на достаточную глубину, зонд прокручивают, чтобы собрать выделения, затем извлекают и оставляют в пробирке для отправки в лабораторию. Пробирка обязательно должна иметь 100% стерильность.
На саму процедуру затрачивается всего несколько минут. Результат доктор может озвучить в течение одной недели, но, обычно на это уходит от двух до трех дней.
В большинстве случаев во время данной манипуляции возможен определенный дискомфорт. Хотя некоторые пациенты могут ощущать болевые симптомы и после процедуры в течение нескольких часов, после чего они сами по себе проходят, без дополнительного вмешательства. Но, если боль не проходит, а только усиливается, и появились гнойные выделения после соскоба – об этом безотлагательно следует поведать врачу.
Для снижения возможных неприятных ощущений урологи часто советуют накануне сдачи анализа провести массаж простаты или же самого канала.
Вопрос-ответ

Что такое посев в урологии?
Посев из уретры у мужчин — это простой и доступный по цене способ диагностики заболеваний органов мочеполовой системы. Его результаты позволяют оценить состав микрофлоры, количественное соотношение в ней патогенных и условно-патогенных микроорганизмов и превышенные нормы их содержания.
Какие болезни может показать бак посев мочи?
Кишечная палочка, фекальный энтерококк, синегнойная палочка, протей мирабилис, цитробактеры, клебсиелла пневмонии, серрация, золотистый и эпидермальный стафилококки, Ещё

Как делают урологический мазок?
Урологический мазок берется у мужчин со слизистой оболочки уретры специальным стерильным зондом (щеточкой, ватным тампоном). Его аккуратно вводят примерно на 3-4 см в уретральный канал. При этом пациент может испытывать незначительную болезненность или неприятные ощущения.
Для чего берут бак посев у мужчин?
Бак посев спермы позволяет выявить полезные бактерии, которые формируют микрофлору, условно-патогенную и патогенную флору.
Советы
СОВЕТ №1
Перед проведением урологического посева обязательно проконсультируйтесь с врачом. Это поможет вам понять, какие именно анализы необходимы и как правильно подготовиться к процедуре для получения наиболее точных результатов.
СОВЕТ №2
Соблюдайте правила гигиены перед сдачей анализа. Это включает в себя тщательное мытье половых органов, чтобы избежать загрязнения образца, что может повлиять на результаты посева.
СОВЕТ №3
Обратите внимание на время сбора образца. Для получения наиболее точных результатов лучше всего сдавать анализ утром, когда концентрация бактерий в моче максимальна.
СОВЕТ №4
Не забывайте о важности последующего анализа результатов. Обсудите с врачом, какие шаги предпринять в зависимости от выявленных бактерий и их чувствительности к антибиотикам.